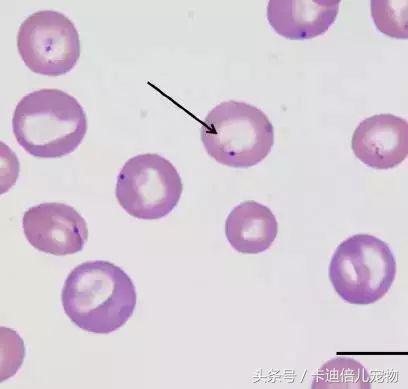
巴贝斯焦虫的终末宿主,巴贝斯焦虫病能扛过去吗
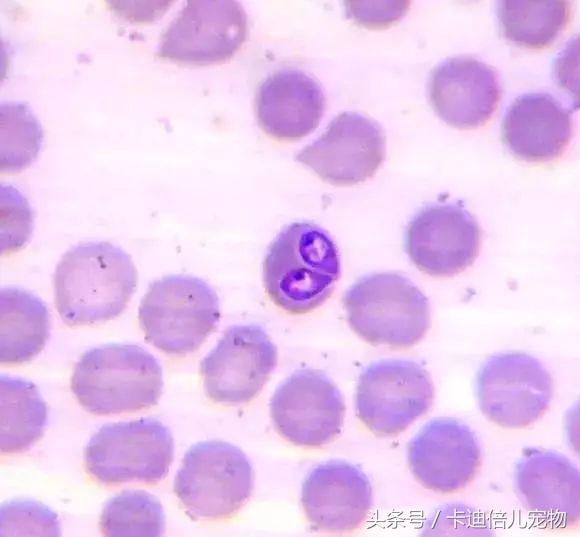
巴贝斯焦虫的终末宿主,巴贝斯焦虫病能扛过去吗

犬巴贝斯虫(焦虫)病
犬巴贝斯虫病是一类世界广泛流行的蜱传播原虫病,巴贝斯虫寄生于犬红细胞中,动物临床可表现为贫血、可视黏膜苍白、黄疸、脾脏肿大、高热、呼吸困难等症状[1-5]。近年来临床甚至出现了耐药虫株,严重加大了临床治疗难度。
病原:
巴贝斯虫是一种蜱传播性原虫,硬蜱是其传播的主要媒介,在蜱吸血时随唾液一起进入哺乳动物的皮肤,侵入红细胞。目前世界流行的巴贝斯虫主要包括两种:犬巴贝斯虫(Babesia canis)和吉氏巴贝斯虫(Babesia gibsoni),其中犬巴贝斯虫是常见的大巴贝斯虫,分为三种亚型,分别为B. canis vogeli(韦氏巴贝斯虫)、B. canis canis和B. canis rossi。韦氏巴贝斯虫通过扇头蜱属(Rhipicephalus)血红扇头蜱(Rhipicephalus Sanguineus)传播,易生长于温暖、潮湿的环境,全年都有该病原体引起地方性流行病的报道。在非洲、亚洲、澳洲、欧洲和美洲都已证实有韦氏巴贝斯虫的存在。在美国南部地区,韦氏巴贝斯虫病是最常见的疾病之一,其流行率从3.8%增长至59%。B. canis canis 主要流行于欧洲,由革蜱属(Dermacentor)网纹革蜱(Dermacentor Reticulatus)传播,但也有分子生物学证据显示扇头蜱属蜱虫也是其传播媒介。B. canis rossi流行于非洲,由血蜱属(Haemaphysalis)传播。吉氏巴贝斯虫通过血蜱属二棘血蜱(Haemaphysalis Bispinosa)和长角血蜱(Haemaphysalis Longicornis)传播,该病原体在世界广泛传播,流行于非洲、亚洲、澳洲、南美州、北美洲以及欧洲。根据媒介的不同,吉氏巴贝斯虫又分为蜱传播和犬与犬之间的传播。例如在美国一些不存在易感蜱虫的地区,主要是通过犬只之间的撕咬传播。在我国,主要流行的巴贝斯虫主要为吉氏巴贝斯虫,其次为犬巴贝斯虫,犬巴贝斯虫中又以韦氏巴贝斯虫为主[3,6-12]。

FIG.1 (摘自《Infection diseases of the dog and cat》)
犬巴贝斯虫生活史:A. 蜱虫吸血时,孢子体随唾液进入宿主血液,通过膜内陷和溶解侵入红细胞 B. 孢子体分化为裂殖子 C. 滋养体呈多形型,在红细胞内进行二分裂,引起红细胞溶解,这种无性繁殖的方式会产生更多裂殖子 D. 裂殖子释放到血液中,感染更多红细胞 E. 蜱虫吸血约10小时后,蜱虫肠道出现虫体 F. 虫体侵入蜱肠上皮细胞经多次分裂形成配子,两个不同虫体的配子结合后形成合子 G. 合子穿入蜱肠,进入血淋巴,随后移入唾液腺 H. 孢子体在唾液腺中复制最终释放到蜱虫唾液中 I. 虫体在雌蜱生殖系统中经卵传播。
TAB. 1常见巴贝斯虫分类、形态及媒介信息(摘自《Infection Diseases of the Dog and Cat》)


FIG.2严重感染血红扇头蜱犬只(图片来源:《Canine Vector-borne Diseases in Brazil》,Filipe Dantas-Torres,2008)
临床症状:
犬被蜱虫叮咬感染巴贝斯虫到表现出临床症状大概需要两周左右,且感染巴贝斯虫的犬可表现出亚临床轻微症状,慢性经过或者急性严重的临床症状,主要取决于动物感染的巴贝斯虫的种类以及动物自身的状况包括:免疫状况、年龄、是否有脾脏切除及其他并发感染[13-14]。各种巴贝斯虫感染后临床主要症状见TAB.2。
TAB2. 不同型巴贝斯虫临床症状(《A Review of Canine Babesiosis: the European Perspective》)


FIG.3感染吉氏巴贝斯虫犬巩膜黄染(图片来源:《Infection Diseases of the Dog and Cat》)
实验室诊断:
镜检:直接显微镜镜检操作简单、方便、快捷,但对于慢性经过或者携带不发病的患犬检出率较低[15]。镜检时一般选择姬姆萨染色血涂片后观察,如发现虫体即可确诊。吉氏巴贝斯虫属于小型巴贝斯虫,多呈环形戒指样,在我国分布最为广泛;犬巴贝斯虫属于大巴贝斯虫,虫体较大,一般长4~5μm,典型虫体为双梨籽形,两虫尖端以锐角相连,每个红细胞内的虫体数目为1~16个。
FIG.4小型焦虫(吉氏巴贝斯虫,箭头所指)镜像下形态,标尺:10µm
(图片来源:《A Review of Canine Babesiosis: the European Perspective》,Laia Solano-Gallego,2016)
FIG.5大型焦虫(犬巴贝斯虫)镜下形态
(图片来源:《Canine Vector-borne Diseases in Brazil》,Filipe Dantas-Torres,2008)
PCR检测:PCR检测与直接镜检相比敏感度更高,即血液中极其微量的虫体也能通过该法检验出来,此外PCR方法与基因测序方法相结合还可对巴贝斯虫进行分型以及耐药基因检测。取病犬EDTA抗凝血全血,利用PCR技术可与其他贫血性疾病(犬埃里希体病)鉴别诊断。检测中心目前开展了两种犬巴贝斯虫检测:吉氏巴贝斯虫检测和犬巴贝斯虫检测(不分型)。诊断流程详见FIG.6。

FIG.6巴贝斯虫实验室诊断流程
药物选择:
不同药物对于不同种类的焦虫存在一定的差异,需要根据犬感染的巴贝斯虫种类进行选择,具体用药指导见TAB.3。
TAB.3 犬巴贝斯虫感染的用药选择(摘自《Infection Diseases of the Dog and Cat》)

IM:肌肉注射;IV:静脉注射;PO:口服;SC:皮下注射;“+++”:效果很好;“++”:效果较好;“+”:效果一般;“—”:无效;“?”:效果未知
a:有关每种药物的具体的信息,请参见药品附录中的相关规定。
b:用药剂量
c:联合用药时可考虑三氮脒和咪多卡联合使用以彻底清除感染,其中三氮脒用量为3.5 mg/kg,咪多卡6.0 mg/kg。
d:表中所列剂量可有效治疗犬巴贝斯虫感染,治疗吉氏巴贝斯虫感染时需24小时内重复用药。7mg/kg或者更高的剂量会增加肾毒性和神经毒性的危险。低剂量2mg/kg曾经被用于预防感染。
e:该种药物在美国禁止使用,但在其他国家如法国则被使用,通用名为:Oxopirvedine,并且与oxomemazin echlorhydrate联合使用。
f:两种药物需联合应用。阿奇霉素在口服时需给动物饲喂高脂肪食物,以促进药物吸收,药物可能会引起轻微的胃肠道症状。该种药物对微小巴贝斯虫引起的人和仓鼠的感染同样有效,并且与阿托伐醌联合应用时治疗犬吉氏巴贝斯虫的感染具有良好的效果。
g:研究表明该药对犬巴贝斯虫感染有一定的疗效,但不足以清除感染。为防止耐药性的产生,不建议单独用药,与其他药物的联合应用的效果还需进一步的验证。
h:该药只能降低或者预防患犬治疗期间寄生虫血症的发生。曾经有人将该药与克林霉素及甲硝锉联合应用于吉氏巴贝斯虫的感染,但是需要更多病例的研究。
参考文献
[1] 张西臣, 赵权.动物寄生虫病学[M]. 吉林人民出版社, 2005: 317-319.
[2] 谷均相, 于庆祥, 王录来, 等. 犬巴贝斯虫病[J]. 中国兽医杂志, 2001, 37(3): 42.
[3] Greene CE. Infection diseases of the dog and cat[M].4th edition, chapter 9, feline parvovirus infection, 774-778.
[4] 迈克尔.沙尔. 新编犬猫疾病诊疗图谱[M]. 辽宁科学技术出版社, 2011年5月第一版, 2.
[5] 胡延春. 犬猫疾病类症鉴别诊疗彩*图色**谱[M].中国农业出版社, 2010年1月第一版, 263
[6] 何英, 叶俊华. 宠物医生手册 [M]. 辽宁科学技术出版社, 2009年8月第一版, 188.
[7] Miller SA, Hohenhaus AE, Hale AS. Case-control study of blood type breed, sex, and bacteremia in dogs with immune-mediated hemolytic anemia [J]. American Veterinary Medicine Association. 2004, 224(2): 232-235
[8] 王绍琛, 钱存忠. 犬巴贝斯虫病的调查与防制[J].畜牧兽医, 2004, 36 (9): 29-30.
[9] Inokuma H, Yoshizaki Y, Matsumoto K, et al. Molecular survey of Babesia infection in dogs in Okinawa, Japan[J]. Vet. Parasitol. 12(1): 341-346.
[10] 冯小兰,庞雪林,施振声. 运用半巢氏PCR检测方法对区域犬焦虫感染状况调查[J].养犬,2014,95(3): 5-12.
[11] Carret C, Delbecq S, Labesse G, Carcy B, Precigout E, et al. Characterization and molecular cloning of an adenosine kinase from Babesia canis rossi. Eur JBiochem. 1999;265:1015-21.
[12] Solano-Gallego L, Baneth G. Babesiosis in dogs and cats - expandingparasitological and clinical spectra. Vet Parasitol. 2011;181:48-60.
[13] Yeagley T J, Reichard M V, Hempstead J E, et al. Detection of Babesia gibsoni and the canine small Babesia ‘Spanish isolate’ in blood samples obtained from dogs confiscated from dog fighting operations[J]. J. Am. Vet. Med. Assoc. 2009, 23(5): 535-539.
[14] Irwin PJ. Canine babesiosis: from molecular taxonomy to control. ParasitVectors. 2009;2 Suppl 1:S4.
[15] Laia Solano-Gallego,Ángel Sainz,Xavier Roura. A review of canine babesiosis: theEuropean perspective. Parasites & Vectors.2016,336(9).